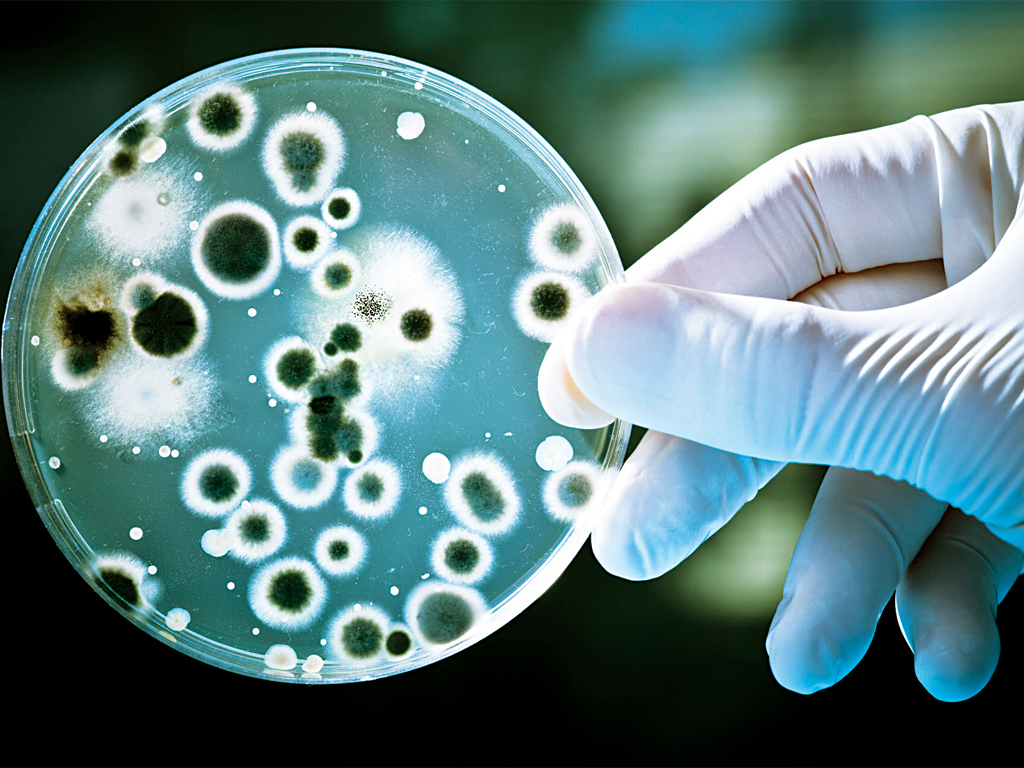

Information related to Rash from antibiotics
People round the world should buy antibiotics over the counter in regular pharmacies. The popularity and therefore the relative convenience of antibiotics have resulted in their usually misuse or overuse. It does not increase the efficacy of treatment and causes side effects. Rash and other skin diseases are a natural body reaction to the antibiotics … Continue reading Information related to Rash from antibiotics